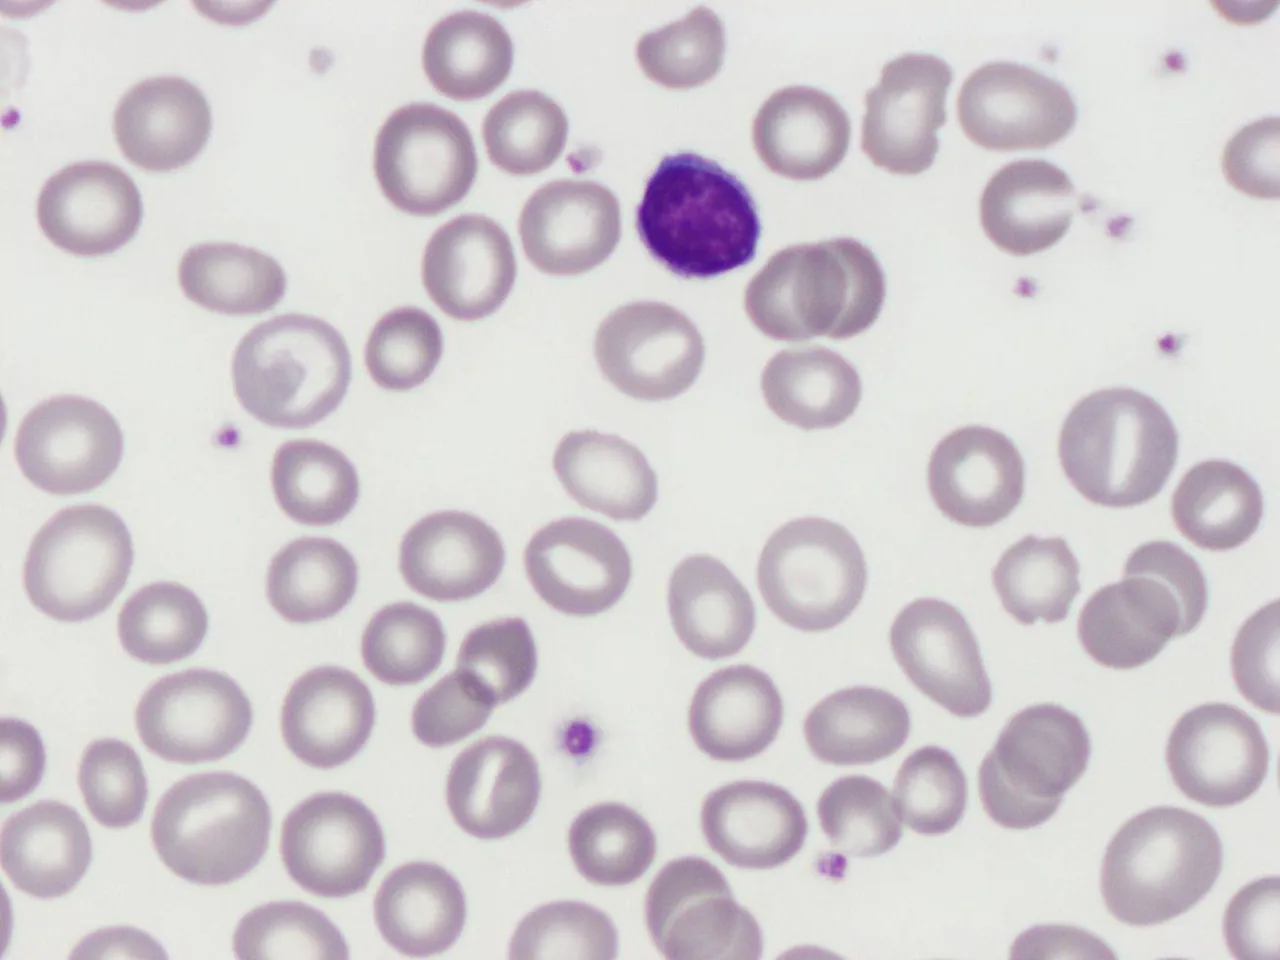
Makrocyty mikrocyty por&oacute;wnanie

Wskaźnik MCV, czyli średnia objętość krwinki czerwonej, to jeden z kluczowych parametrów, który znajdziesz w wynikach swojej morfologii krwi. Jego zrozumienie jest niezwykle ważne, ponieważ dostarcza cennych informacji o stanie zdrowia, zwłaszcza w kontekście diagnostyki niedokrwistości. W tym artykule, jako Piotr Lewandowski, ekspert w dziedzinie tworzenia treści medycznych, przeprowadzę Cię przez meandry interpretacji wyników MCV, pomagając zrozumieć, co oznaczają wartości powyżej i poniżej normy.
MCV to średnia objętość krwinki czerwonej kluczowy wskaźnik w diagnostyce niedokrwistości.
- MCV (Mean Corpuscular Volume) określa średnią objętość erytrocytu i jest wyrażane w femtolitrach (fl).
- Prawidłowe wartości MCV dla dorosłych to zazwyczaj 82-96 fl, ale normy mogą się różnić w zależności od laboratorium, wieku i ciąży.
- Podwyższone MCV (makrocytoza) najczęściej wskazuje na niedobór witaminy B12 lub kwasu foliowego, nadużywanie alkoholu lub choroby wątroby.
- Obniżone MCV (mikrocytoza) jest typowe dla niedokrwistości z niedoboru żelaza lub talasemii.
- Interpretacja MCV zawsze wymaga analizy w kontekście innych parametrów morfologii (MCH, MCHC, RDW) oraz konsultacji z lekarzem.
- Nieprawidłowy wynik MCV zawsze wymaga dalszej diagnostyki i profesjonalnej interpretacji, nie należy samodzielnie stawiać diagnozy.
Czym dokładnie jest wskaźnik MCV i dlaczego jest tak ważny?
MCV, czyli z angielskiego Mean Corpuscular Volume, to parametr określający średnią objętość pojedynczej krwinki czerwonej, czyli erytrocytu. Mierzy się go w femtolitrach (fl). Jest to niezwykle istotny wskaźnik, ponieważ pomaga lekarzom w diagnostyce różnicowej niedokrwistości, czyli anemii. Dzięki niemu można określić, czy krwinki czerwone są prawidłowej wielkości, czy też są zbyt małe (mikrocytoza) lub zbyt duże (makrocytoza). To rozróżnienie jest kluczowe, gdyż różne typy niedokrwistości mają odmienne przyczyny i wymagają innego leczenia.
Jaką rolę pełnią krwinki czerwone w Twoim organizmie?
Aby w pełni zrozumieć znaczenie MCV, warto przypomnieć sobie podstawową rolę krwinek czerwonych. Erytrocyty to prawdziwi "kurierzy" w naszym ciele. Ich głównym zadaniem jest transport tlenu z płuc do wszystkich tkanek i narządów, a także odbieranie z nich dwutlenku węgla i przenoszenie go z powrotem do płuc, skąd jest wydalany. Prawidłowa wielkość i kształt krwinek czerwonych są niezbędne do efektywnego pełnienia tej funkcji. Jeśli krwinki są zbyt małe lub zbyt duże, ich zdolność do przenoszenia tlenu może być upośledzona, co prowadzi do objawów niedokrwistości.

Jakie są prawidłowe normy MCV?
Dla większości dorosłych osób prawidłowe wartości referencyjne MCV mieszczą się zazwyczaj w przedziale 82-96 femtolitrów (fl). Warto jednak pamiętać, że te normy mogą się nieznacznie różnić w zależności od konkretnego laboratorium, które wykonuje badanie. Zawsze należy odnosić swój wynik do zakresu podanego na wydruku z laboratorium.
Czy normy MCV dla dzieci i kobiet w ciąży wyglądają inaczej?
Tak, normy MCV nie są stałe dla wszystkich grup wiekowych i stanów fizjologicznych. U noworodków i małych dzieci wartości MCV są zazwyczaj wyższe niż u dorosłych, mogą sięgać nawet 120 fl, a następnie stopniowo maleją wraz z wiekiem. U kobiet w ciąży natomiast może wystąpić fizjologiczny, niewielki wzrost MCV, co jest związane ze zmianami hormonalnymi i zwiększoną objętością krwi.
Dlaczego wartości referencyjne mogą różnić się między laboratoriami?
Różnice w normach referencyjnych MCV między laboratoriami wynikają z kilku czynników. Po pierwsze, każde laboratorium może używać nieco odmiennych metod badawczych i sprzętu. Po drugie, normy te są często ustalane na podstawie badań populacji referencyjnych, które mogą się różnić demograficznie. Dlatego tak ważne jest, aby zawsze interpretować swój wynik w odniesieniu do zakresu norm podanego na konkretnym wyniku badania.
Podwyższone MCV (makrocytoza) co oznaczają zbyt duże krwinki?
Gdy wynik MCV przekracza górną granicę normy (zazwyczaj >96 fl), mówimy o makrocytozie, co oznacza, że krwinki czerwone są większe niż normalnie. Taki stan zawsze wymaga dalszej diagnostyki, ponieważ może wskazywać na szereg problemów zdrowotnych.
Niedobór witaminy B12 i kwasu foliowego najczęstszy winowajca
Najczęstszą przyczyną makrocytozy jest niedokrwistość megaloblastyczna, która wynika z niedoboru witaminy B12 i/lub kwasu foliowego. Te witaminy są absolutnie niezbędne do prawidłowej syntezy DNA w komórkach szpiku kostnego, w tym w prekursorach krwinek czerwonych. Ich brak prowadzi do tego, że komórki nie mogą się prawidłowo dzielić, stają się większe i niedojrzałe, co skutkuje produkcją dużych, ale niefunkcjonalnych erytrocytów. Niedobory te mogą być spowodowane nieodpowiednią dietą, zaburzeniami wchłaniania lub niektórymi lekami.
Jak alkohol i choroby wątroby wpływają na wzrost MCV?
Nadużywanie alkoholu jest kolejną częstą przyczyną podwyższonego MCV. Alkohol może bezpośrednio uszkadzać szpik kostny, zaburzając produkcję krwinek, a także prowadzić do niedoborów witaminy B12 i kwasu foliowego. Podobnie, przewlekłe choroby wątroby, takie jak marskość, często wiążą się z makrocytozą. Wątroba odgrywa kluczową rolę w metabolizmie wielu substancji, a jej uszkodzenie może wpływać na procesy krwiotwórcze oraz prowadzić do zmian w błonach komórkowych erytrocytów, zwiększając ich objętość.
Niedoczynność tarczycy a morfologia krwi: co musisz wiedzieć?
Zaskakujące dla wielu, ale niedoczynność tarczycy również może być przyczyną podwyższonego MCV. Hormony tarczycy mają wpływ na metabolizm i funkcjonowanie wielu komórek w organizmie, w tym na komórki szpiku kostnego. Ich niedobór może spowalniać procesy dojrzewania erytrocytów, prowadząc do ich powiększenia.
Kiedy wysokie MCV może być zjawiskiem fizjologicznym?
- Ciąża: Jak już wspomniałem, niewielki wzrost MCV w ciąży jest często zjawiskiem fizjologicznym i nie powinien budzić niepokoju.
- Wzmożona retikulocytoza: Retikulocyty to młode formy krwinek czerwonych, które są nieco większe niż dojrzałe erytrocyty. Jeśli szpik kostny intensywnie produkuje nowe krwinki (np. po krwotoku, w niedokrwistości hemolitycznej), ich zwiększona liczba może tymczasowo podnieść średnią objętość MCV.
- Nowotwory szpiku kostnego: W niektórych rzadkich przypadkach, takich jak zespoły mielodysplastyczne, podwyższone MCV może być jednym z pierwszych sygnałów poważniejszych zaburzeń szpiku kostnego.
Obniżone MCV (mikrocytoza) co oznacza, gdy krwinki są za małe?
Jeżeli wynik MCV spada poniżej dolnej granicy normy (zazwyczaj <82 fl), mówimy o mikrocytozie, czyli stanie, w którym krwinki czerwone są mniejsze niż powinny. Jest to równie ważny sygnał diagnostyczny jak makrocytoza i również wymaga dalszej analizy.
Niedokrwistość z niedoboru żelaza jako główna przyczyna niskiego MCV
Absolutnie najczęstszą przyczyną mikrocytozy jest niedokrwistość z niedoboru żelaza, zwana również anemią syderopeniczną. Żelazo jest kluczowym składnikiem hemoglobiny, białka odpowiedzialnego za transport tlenu. Kiedy brakuje żelaza, szpik kostny nie jest w stanie wyprodukować wystarczającej ilości hemoglobiny, a krwinki czerwone stają się mniejsze i bledsze. Niedobór żelaza może wynikać z niewystarczającej podaży w diecie, zwiększonego zapotrzebowania (np. w ciąży, u dzieci), ale najczęściej jest efektem przewlekłej utraty krwi (np. obfite miesiączki, krwawienia z przewodu pokarmowego).
Talasemia i inne uwarunkowania genetyczne kiedy warto je podejrzewać?
Inną ważną przyczyną mikrocytozy, szczególnie w populacjach o określonym pochodzeniu etnicznym (np. basen Morza Śródziemnego, Azja Południowo-Wschodnia), jest talasemia. Jest to genetycznie uwarunkowane zaburzenie syntezy hemoglobiny, które prowadzi do produkcji małych, niedobarwionych krwinek czerwonych. Talasemia jest chorobą wrodzoną i często przebiega bezobjawowo lub z łagodnymi objawami, ale może prowadzić do poważnych problemów zdrowotnych. Warto ją podejrzewać, gdy mikrocytoza występuje od wczesnego dzieciństwa i nie ma cech niedoboru żelaza.
Czy przewlekły stan zapalny może obniżyć Twoje MCV?
Tak, niedokrwistość chorób przewlekłych (ACD) to kolejny powód obniżonego MCV. W przebiegu długotrwałych stanów zapalnych, takich jak reumatoidalne zapalenie stawów (RZS), choroby zapalne jelit (np. choroba Leśniowskiego-Crohna, wrzodziejące zapalenie jelita grubego) czy niektóre nowotwory, organizm może mieć problem z efektywnym wykorzystaniem żelaza, mimo że jego zapasy są prawidłowe. Prowadzi to do zaburzeń w produkcji hemoglobiny i w konsekwencji do powstania małych krwinek.
Jak interpretować MCV? Kluczowe powiązania z innymi parametrami krwi
Jako ekspert zawsze podkreślam, że pojedynczy parametr, taki jak MCV, nigdy nie powinien być interpretowany w oderwaniu od całej morfologii krwi. To tak, jakby próbować ocenić książkę po jednym słowie. Pełny obraz dają dopiero powiązania MCV z innymi wskaźnikami.
MCV, MCH, MCHC jak czytać te wskaźniki razem?
MCV jest częścią triady wskaźników czerwonokrwinkowych, które pomagają w różnicowaniu niedokrwistości. Obok MCV mamy:
- MCH (Mean Corpuscular Hemoglobin): średnia masa hemoglobiny w pojedynczej krwince czerwonej.
- MCHC (Mean Corpuscular Hemoglobin Concentration): średnie stężenie hemoglobiny w krwince czerwonej.
Co mówi o Twoich krwinkach wskaźnik RDW?
RDW (Red Cell Distribution Width) to kolejny niezwykle przydatny wskaźnik, który mierzy zróżnicowanie objętości krwinek czerwonych. Innymi słowy, informuje nas, czy wszystkie krwinki są podobnej wielkości, czy też występują duże różnice między nimi. Wysokie RDW oznacza, że krwinki są bardzo zróżnicowane pod względem rozmiaru (anizocytoza). Jest to często wczesny sygnał niedokrwistości z niedoboru żelaza, gdzie początkowo pojawiają się małe krwinki obok tych o prawidłowej wielkości. W talasemii natomiast, mimo mikrocytozy, RDW często pozostaje w normie, ponieważ wszystkie krwinki są jednolicie małe. To subtelne rozróżnienie jest bardzo pomocne w diagnostyce.
Dlaczego pełna morfologia to podstawa trafnej diagnozy?
Ostatecznie, aby postawić trafną diagnozę, niezbędna jest analiza wszystkich parametrów morfologii krwi, w tym liczby erytrocytów (RBC) i poziomu hemoglobiny (HGB). To właśnie poziom hemoglobiny jest głównym wskaźnikiem niedokrwistości. MCV, MCH, MCHC i RDW są narzędziami, które pomagają określić jej typ i potencjalną przyczynę. Zawsze pamiętaj, że tylko kompleksowa ocena pozwala na prawidłową interpretację i uniknięcie błędnych wniosków.
Nieprawidłowy wynik MCV co robić i jakie badania wykonać dalej?
Jeśli Twój wynik MCV jest poza normą, najważniejszą rzeczą, jaką możesz zrobić, jest konsultacja z lekarzem. Samodzielna interpretacja, choć kusząca, może prowadzić do niepotrzebnego stresu lub, co gorsza, do zbagatelizowania poważnego problemu. Lekarz, znając Twój wywiad medyczny i objawy, zleci odpowiednie dalsze badania.
Jakie dodatkowe badania pomogą ustalić przyczynę problemu?
- Poziom żelaza i ferrytyny: Kluczowe w diagnostyce niedokrwistości z niedoboru żelaza. Ferrytyna odzwierciedla zapasy żelaza w organizmie.
- Poziom witaminy B12 i kwasu foliowego: Niezbędne do potwierdzenia lub wykluczenia niedokrwistości megaloblastycznej.
- Badanie szpiku kostnego: W bardziej złożonych przypadkach, gdy inne badania nie dają jednoznacznej odpowiedzi, lekarz może zdecydować o wykonaniu biopsji szpiku kostnego.
- Badania funkcji tarczycy: W przypadku podejrzenia niedoczynności tarczycy.
- Badania w kierunku chorób przewlekłych: Jeśli istnieje podejrzenie niedokrwistości chorób przewlekłych.
Dlaczego samodzielna interpretacja wyników w internecie to zły pomysł?
Internet jest skarbnicą wiedzy, ale w kwestiach zdrowotnych może być również źródłem dezinformacji i niepotrzebnego lęku. Samodzielne stawianie sobie diagnoz na podstawie pojedynczych wyników badań i fragmentarycznych informacji z sieci jest ryzykowne. Diagnostyka medyczna to złożony proces, który wymaga wiedzy, doświadczenia i uwzględnienia wielu czynników, w tym Twojego stanu klinicznego, objawów i historii chorób. Zawsze powierz interpretację wyników specjaliście.
Jak przygotować się do badania krwi, aby wynik MCV był wiarygodny?
Prawidłowe przygotowanie do badania krwi jest ważne, aby uzyskane wyniki były jak najbardziej wiarygodne i odzwierciedlały rzeczywisty stan Twojego organizmu.Czy na badanie morfologii trzeba być na czczo?
W przypadku samej morfologii krwi, w tym oznaczenia MCV, nie ma bezwzględnego wymogu bycia na czczo. Jednakże, jeśli jednocześnie z morfologią będziesz miał oznaczane inne parametry, takie jak glukoza, profil lipidowy czy enzymy wątrobowe, zaleca się, aby na badanie zgłosić się na czczo (po 8-12 godzinach od ostatniego posiłku). Wypicie szklanki wody jest dozwolone, a nawet wskazane, aby ułatwić pobranie krwi.
Przeczytaj również: Spirometria: Gdzie wykonać, ile kosztuje i jak się przygotować?
Jakie czynniki mogą tymczasowo zaburzyć wynik MCV?
- Niektóre leki: Przyjmowanie pewnych leków (np. chemioterapeutyków, leków przeciwpadaczkowych) może wpływać na wielkość krwinek. Zawsze poinformuj lekarza o wszystkich przyjmowanych medykamentach.
- Wzmożona retikulocytoza: Jak już wspomniałem, zwiększona produkcja młodych krwinek po krwotoku lub w niedokrwistości hemolitycznej może tymczasowo podnieść MCV.
- Stan nawodnienia organizmu: Skrajne odwodnienie lub przewodnienie może w pewnym stopniu wpływać na objętość krwinek, choć w przypadku MCV wpływ ten jest zazwyczaj niewielki.
- Niedawne przetoczenie krwi: Może wpłynąć na parametry morfologii, w tym MCV.
